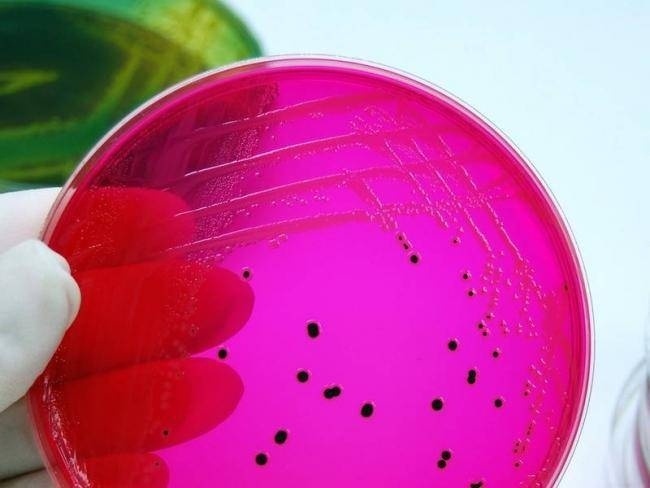

Санитарные врачи нашли человека, который отравил больше двадцати астанчан. Как выяснилось, столичный предприниматель производила сладости и сбывала свою продукцию в супермаркет без каких-либо на то разрешений.
Мини-цех, где пекли некачественные пирожные, немедленно закрыли. Специалисты выявили там массу нарушений. Еду готовили в антисанитарных условиях. Десерты на витринах тут же ликвидировали. Теперь, по всей видимости, директору магазина и кондитеру придется несладко. Пострадавшие намерены подавать на них в суд. Покупатели хотят наказать бизнесменов на тринадцать миллионов тенге. Напомню, 22 человека оказались в больнице после того, как съели заварные пирожные. У пациентов врачи диагностировали сальмонеллез.
- Выявлены нарушения и в самом магазине, и в цехе. Это нарушения отсутствия журнала здоровья. Были отобраны пробы на лабораторные исследования, обследованы двадцать восемь человек на носительство патогенной флоры. Из них шесть человек отстранены от работы, потому что у них не было допуска к работе -медицинской книжки, - зяявил Нурлыбек Асылбеков, руководитель Департамента по защите прав потребителей Астаны